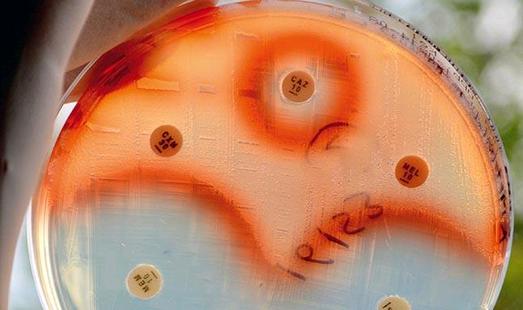

Kırklareli’nin Lüleburgaz ilçesinde 1985 yılında kurulan 1.156 MW kapasiteli Hamitabat Doğalgaz Kombine Çevrim Santrali, Türkiye’nin ilk doğalgaz kombine çevrim santrali olma özelliğini taşıyor. Yıllık 5,5 milyar kWh üretimiyle 1,7 milyon…
Devamını Oku »Haberler
Güncel haberler ve sondakika haberler yer almaktadır.
Biyogüveııük Kanunu ile GDO’lu ürünlerin Türkiye’de üretilmesi ya da ithalatmm yasaklanmasıyla nişasta üretiminde kullanılan enzimler de bu kapsama girdi, ithalatm yapıldığı ülkelerden ‘Hem enzim hem de üretildiği migroorganizma için GDO…
Devamını Oku »Yenilenen kopseptiyle “yaratıcı endüstrilerin” yanı sıra, bu yıl ilk defa ‘‘gelişen teknolojiler” konusunu da ele alacak olan alldesign Yaratıcı Endüstriler ve Gelişen Teknolojiler Fuarı & Uluslararası Tasarım Konferansları, 19-21 Şubat…
Devamını Oku »Evet, ama çok daha fazla nakit para ve beklentilerde büyük bir değişim gerekecek. Hevesli uzay turistleri Virgin Galactic’in SpaceShipTvvo (SS2) adlı uzay aracına büyük umutlar bağlamış ve gelecekte yörünge altına…
Devamını Oku »Paul Gingsparg tarafından 1991de kurulan arXiv, başlangıçta sadece yüksek enerji fiziği alanında çalışan yüz kadar arkadaşın çalışmalarını paylaşabileceği elektronik bir bülten olarak tasarlanmıştı. Bugünse fizik, matematik ve bilgisayar bilimleri alanında…
Devamını Oku »ELEKTRİKLİ BİSİKLET İMALATÇISI Elektrikli bisiklet tutkunu Micah TolL, üniversiteden sonra Tel Aviv’e taşındı ve bisiklet tamirciliği yaparken e-bisikletlerin arızalarını öğrendi. Şimdi bu bilgiyi kullanarak daha iyi modeller yapıyor, sıradan motosikletleri…
Devamını Oku »2014 Aralık ayında eğitime başlayan okulun resmi açılış töreni 16 Ocak 2015 tarihinde İTÜ Taşkışla Yerleşkesi Bilim Merkezinde, öğrencilerin ve projenin paydaşı olan tüm kurum ve kuruluşların katılımıyla gerçekleştirildi. İstanbul…
Devamını Oku »Proje kapsamında gerçekleştirilen laboratuvar analizleri sonucunda, farklı hayvan gübrelerinden ve hayvan gübresinin kullanıldığı tarım arazilerindeki topraktan alınan örneklerde en az bir tip antibiyotik kirliliği tespit edildi. Ayrıca gübre örneklerindeki antibiyotik…
Devamını Oku »S.Ü. Sakıp Sabancı Müzesi’nin Çocuk Eğitimi m Programları, sömestr ta- \ tilini eğlenceli bir sanat molasına dönüştürüyor, 6-10 yaş arası tüm çocukların katılabileceği ve yarıyıl tatili boyunca devam edecek eğitimler,…
Devamını Oku »